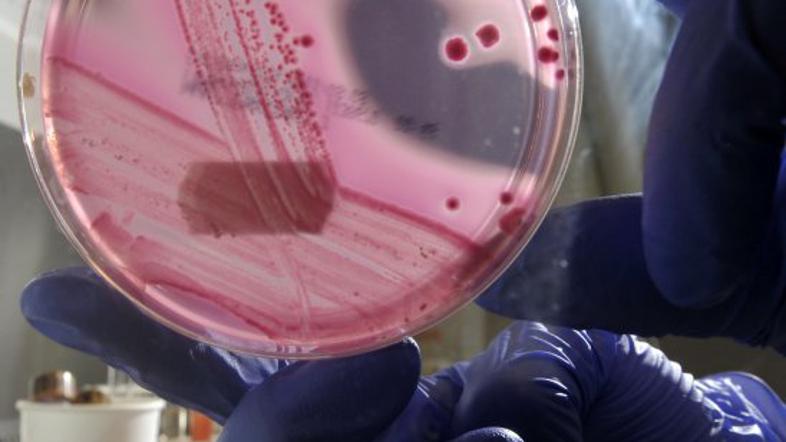
bakterija

Gre za bakterijo bacillus F, katere protein upočasni staranje, je objavila Ruska akademija znanosti. Znanstveniki so opravili testiranja pri miših in ugotovili, da se jim je življenjska doba podaljšala za 308 dni. Povprečna življenjska doba miši je sicer 589 dni.
Pri človeku bi to lahko pomenilo, da bi lahko živel 140 let, povzetke raziskave povzema francoski Le Figaro. Poleg tega pa bakterija povzroči tudi hitrejše delovanje metabolizma.
Glede na lastnosti proteina in drugih gradnikov izgleda, kot da bakterija v razvoju pred drugimi bakterijami zamuja tri milijone let, pravijo znanstveniki, ki pa ob tem niso povedali, koliko miši je sodelovalo v testiranju.
Bakterija, ki podaljša življenje
Ruski znanstveniki so v Sibiriji odkrili bakterijo, ki upočasni proces staranja. Pri miših so tako ugotovili, da se jim je življenjska doba podaljšala za 308 dni, pospešil pa se jim je tudi metabolizem.




